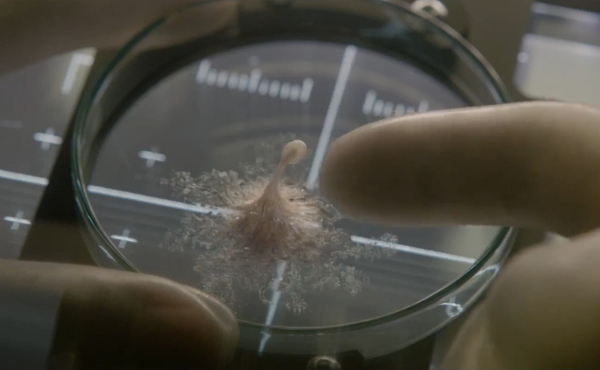

ชื่ออังกฤษ : LIFE
ชื่อไทย :ไลฟ์ สายพันธุ์มฤตยู
ผู้กำกับ : แดเนียล เอสพิโนซ่า
นักแสดงนำ : ไรอัน เรย์โนลด์, เจค จิลเลนฮาล, รีเบคก้า เฟอร์กูสัน
ผู้แต่ง : พอล เวอร์นิค, เร็ทท์ รีส
วันเข้าฉาย : 23 มีนาคม 2560
ประเภท : Sci-Fi, Thriller
ค่ายผู้ผลิต : Sony Pictures Entertainment
ค่ายหนัง : Sony Pictures Releasing International
ความยาว : ไม่ระบุ
เรท : ไม่ระบุ
แสดงนำ : เจค จิลเลนฮาล, ไรอัน เรย์โนลด์, รีเบคก้า เฟอร์กูสัน และฮิโรยูกิ ซานาดะ

ในช่วงที่หนังแนวๆตะลุยอวกาศเริ่มจะมีโผล่มาให้ชมในโรงเป็นระยะๆช่วงสองสามปีให้หลังมานี้ ก็ล้วนเป้นหนังที่มีความน่าสนใจ น่าค้นหา และการวางเรื่องที่ชวนให้ติดตามไม่น้อย ทั้งหนังกึ่งเรียล กึ่งทฤษฎีอย่าง Prometheus / Interstellar ( 2 เรื่องแรกนี้จัดเป็นหนังโปรดของแอดมินเอง 55+) / Martian / Gravity หรือแฟนตาซีสุดขอบอย่าง Star Trek / Starwars 7 ที่เพิ่งเข้าโรงไปเมื่อปีก่อน ก็สร้างสีสันให้วงการภาพยนตร์เป็นอย่างดี
และนี่คือหนังแนว ไซไฟตะลุยอวกาศ อีกหนึ่งเรื่องจากทาง Sony Pictures Entertainment ที่ขอพาทุกท่านดำดิ่งสู่ห้วงอวกาศอีกครั้ง เพื่อค้นหา “ชีวิต” และ “ปริศนา” บนดาวอันห่างไกล กับหนัง Sci-Fi, Thriller ที่ชื่อว่า LIFE
เรื่องย่อ
LIFE บอกเล่าเรื่องราวของลูกเรือ 6 คน ของสถานีอวกาศนานาชาติที่อยู่ในจุดเปลี่ยนของ “การค้นพบที่สำคัญที่สุดในประวัติศาสตร์ของมนุษย์” เมื่อมีการค้นพบหลักฐาน และร่องรอยของ “ชีวิต” บนดาวอังคาร ซึ่งเป็นสิ่งมีชีวิตเซลล์เดียว และ “มัน” จะโชว์ให้เห็นถึงสติปัญญาอันล้ำลึก ที่แฝงด้วยอันตรายยิ่งกว่าที่ใครๆเคยคาดคิด
ตัวหนัง ได้ดาราชื่อดังที่คอหนังรู้จักดีอย่าง เจค จิลเลนฮาล, ไรอัน เรย์โนลด์, รีเบคก้า เฟอร์กูสัน และฮิโรยูกิ ซานาดะ มาร่วมแสดงนำ

ตัวหนังกำกับโดย แดเนียล เอสปิโนซ่า ซึ่งเคยมีผลงานอย่าง Safe House (2012) และ Child 44 (2015) และยังได้ พอล เวอร์นิก และ แรตต์ รีส มือเขียนบทจาก Deadpool มาร่วมงานนี้ด้วย
ถึงแม้ว่าแฟนๆหนังบางส่วนจะเริ่มเอียนกับ “แนวค้นพบเอเลี่ยน” แล้วก็ตาม 55+ แต่ด้วยความน่าสนใจของเทรลเลอร์ที่ถูกปล่อยออกมา ก็มีเสียงตอบรับจากคอหนังอีกกลุ่มว่า “น่าสนใจ” เอาเป็นว่า หนังเข้า 23 มีนาคม 2560 นี้ คอหนังไซไฟก็น่าจะตีตั๋วไปพิสูจน์ในโรงละกันนะครับ
แอดมิน Ak47
Trailer
-
BANDAI เปิดตัวของเล่นไลน์ใหม่ Gundam Cross และ Gundam Miximize#ข่าวของเล่น #Gundam #Bandai #GundamCross #GundamMiximize #Gunpla
-
เจาะลึกของเล่นใหม่ GYAKUTEN BARIBA REVERSE เกมดีดเหรียญวัดพลังจาก Bandai#GyakutenBaribariverse #逆転バリバリバース #Baribariverse #BandaiToys
#เกมดีดเหรียญ #Beyblade #ของเล่นญี่ปุ่น -
ย้อนอดีตเกมดัง Resident Evil Outbreak : เกมซอมบี้ไอเดียดีที่มาก่อนเวลา#ResidentEvil #ResidentEvilOutbreak #Capcom #SurvivalHorror #RaccoonCity #Biohazard #PS2 #OnlineGaming #RetroGaming #ข่าวเกม